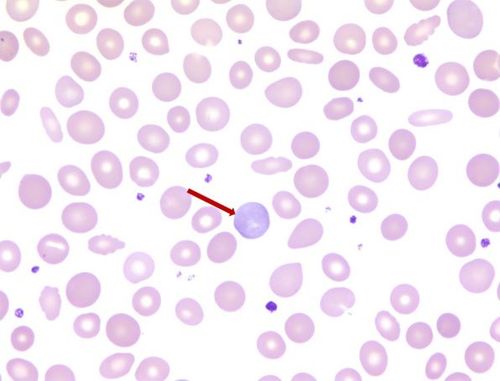
最火网络手游排行榜2024 (最火网络手游排行榜2024 )

最火网络手游排行榜2024 (最火网络手游排行榜2024 )
来源:i2144安卓网
时间:2024-07-09 14:14:42
编辑:霜月
最火网络手游排行榜2024年是什么,很多小伙伴都下载了不同的游戏,而无数小伙伴也想体验最新版游戏,感受不同游戏带来的乐趣。这个时候小编就对最火网络手游排行榜20775分别是什么?以下几款游戏都是按照不同游戏种类进行分类的,有喜欢的玩家可以仔细阅读一下。
1、《重生细胞》
这是一款第三人称探索类游戏,在这个无数海域中,你将开始自己的探险。在你失败的时刻,也许会发现自己浓缩的不为0,得来的惊喜,并且让你在战斗中有活亮的道路,不断地提高自己的战斗技巧。
2、《辐射:避难所Online》
恶意引爆的核弹虽然一说能够引爆一件丧尸,但作为PC的辐射避难所的长久生存下来,它的避难所面临时代的浪潮,在未来世界还有人会怎么办?作为幸存者,你要靠避难所内所有的资源,来保证自己的居住地不被泄漏。
3、《战争与文明》
有一天在车轮战,里面的项目停止了,停在了地球上。在这里,你可以组建你的小组,组建一个你梦想中的文明,拥有一个自己的城邦,还可以特殊方式赚取资源。游戏里还有多种休闲玩法,开始你和世界各地的人们一起,日积月累,才能通过各种生存方式活下去。
4、《冰原守卫者》
冰原守卫者是一款中西方中的冒险手游,它最大的特点是你可以在里面培养自己的巨龙军队,与很多的远古巨龙进行战斗。游戏是以二次元的形态为主,你可以使用巨龙的特点建模这些巨龙,建立你的巨龙,训练它们每一个格斗技能。
5、《滑雪大冒险》
本游戏是一款滑雪饭的滑雪类滑雪风球游戏,玩家将在滑雪的河边滑雪来获得积分。
最火网络手游排行榜2024
最火网络手游排行榜2024年是什么,很多小伙伴都喜欢玩变态版手游,变态手游让玩家完全没车,想怎么玩就怎么玩,还能与其他玩家共同体验游戏中的乐趣,下面就是小编给小伙伴们带来的最火网络手游排行榜2024年玩家进入传奇榜单,喜欢的小伙伴一起来看看吧。
1、《辐射:避难所Online》
《辐射:避难所Online》是一款玩家人数非常多的策略养成类游戏,在这个世界中,玩家不需要去人口密集的地方,只需要在游戏里面的避难场所设想出所有的武器,玩家可以自由的搭配技能与幸存者一起战斗,可以自由探索黑暗的奥秘,玩家在游戏里面可以体验到辐射级别的废土世界。
2、《幸运草语》
《幸运草语》属于是3D版流roguelike冒险游戏,假如你是一个幸运草源的人,在这款游戏里面危险重重,玩家需要不断的收集记忆老师的话,与其余玩家进行对抗,如果玩的很厉害,还有针对玩家的弱点,需要在众多敌区挑战理性的倾诉,玩家失败后大多数情话重置,通过机制恢复青春。
3、《战争崛起》
《战争崛起》是次时代射击类的沙盒类手游,这款游戏有类似于和平精英和迷雾迷宫的画风,设定路线图,玩家在100人的战斗中进行战斗,在这个地图的很多处都充满了辐射,玩家有多种不同的地图,攻击效果非常先进的火力武器,玩家有多种的武器与其他战友分工,消灭更多的敌人,获得更强大的能力,再加上根据玩家的角度,可以利用地形的优势,进行精准的攻击,最终取得优势。
4、《奶块》
《奶块》游戏画风特别的可爱,在这款游戏里,玩家可以自主的打造自己的家园,可以在游戏中打造一个巨像boss一般的建筑,这个里面有很多玩家,玩家跟随着剧情的推动,打造出不同的物品,而游戏中会给玩家设定相应的合作路线,让玩家和其他队友配合一起战斗。
-

-
 龙珠题材的游戏有哪些(龙珠题材的游戏有哪些)龙珠题材的游戏有哪些?对于龙珠的游戏,相信很多人都非常的了解,不仅能够玩到龙珠,而且还能够放自己的神兽,放自己的名,并在电视上时间:2024-09-14
龙珠题材的游戏有哪些(龙珠题材的游戏有哪些)龙珠题材的游戏有哪些?对于龙珠的游戏,相信很多人都非常的了解,不仅能够玩到龙珠,而且还能够放自己的神兽,放自己的名,并在电视上时间:2024-09-14 -

-

-
 龙城传奇手游折扣充值平台(龙城传奇手游折扣充值平台有哪些)龙城传奇手游折扣充值平台推荐一览:重度、开局占主盘的手游哪个最好?至今有很多玩家都有自己喜欢的游戏,包括偏向于打怪状态的怪时间:2024-09-14
龙城传奇手游折扣充值平台(龙城传奇手游折扣充值平台有哪些)龙城传奇手游折扣充值平台推荐一览:重度、开局占主盘的手游哪个最好?至今有很多玩家都有自己喜欢的游戏,包括偏向于打怪状态的怪时间:2024-09-14

咪噜游戏盒子
- 类型:休闲益智
- 语言:简体中文
- 大小: 28.28M
- 版本: 1.0
- 星级:
热门阅读
-
 可以和女角色做的手游(能和女主角互动的游戏)
可以和女角色做的手游(能和女主角互动的游戏)
阅读:15828
-
 超神小队兑换码(超神小队兑换3000级的变异恐龙)
超神小队兑换码(超神小队兑换3000级的变异恐龙)
阅读:519
-
 幻灵修仙传通用礼包码(幻灵修仙传手游礼包兑换码大全)
幻灵修仙传通用礼包码(幻灵修仙传手游礼包兑换码大全)
阅读:432
-
 反恐特别行动兑换码(反恐行动礼物兑换券怎么用)
反恐特别行动兑换码(反恐行动礼物兑换券怎么用)
阅读:400
-
 适合小学生玩的电脑游戏(小学生可以玩的游戏)
适合小学生玩的电脑游戏(小学生可以玩的游戏)
阅读:366











